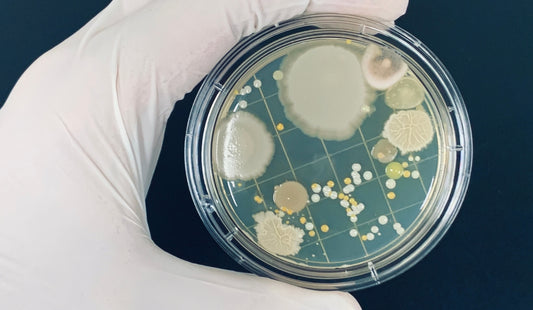
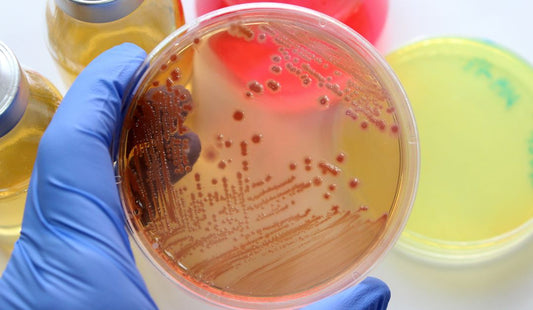

Browse through our list of education series and contact us now!
FC-BIOS
Education Series
Become an expert in your field in no time.
Discover Our Education Series Here
TechTalk

Effective temperature monitoring is critical in maintaining the integrity of sensitive materials in research settings. This training provides valuable insights to optimize cold chain management.

Pipettes are essential tools for precise liquid handling in laboratories. This session offers a guide to improve pipetting techniques and extend equipment lifespan.

Microplate readers are versatile tools for advanced lab analyses. This session covers their modes and applications to enhance their use.

Biobanking is key to preserving biological samples for research and clinical use. This session covers practices and technologies for effective cryopreservation.

ULT freezers are vital for preserving sensitive samples in research and clinical settings. This session offers tips on maintenance and best practices for efficient operation.

Centrifuges are essential for separating substances by density in labs. This session covers maintenance, safety, and tips to extend their lifespan.

Autoclaves are essential for sterilizing in labs and clinics, ensuring safety and meeting regulations. This session explains autoclave safety and how to operate them effectively.
Technical Workshop

This workshop focuses on the essential skills and techniques for effective and safe liquid handling, with an emphasis on pipetting accuracy and ergonomics.

This workshop offers a comprehensive guide to nucleic acid extraction, focusing on foundational concepts and advanced techniques to ensure successful outcomes.

This workshop explores innovative techniques for advancing cell culture methodologies, focusing on scalable and efficient systems for modern research.

This workshop provides an essential introduction to cell culture techniques, focusing on best practices and protocols for maintaining healthy cell lines.
Training Course

This training focuses on advancing endotoxin testing through innovative methodologies, providing a detailed understanding of PYROSMART, a recombinant Cascade Reagent (rCR).
This training is designed for professionals in the pharma industry, focusing on microbiology's role in ensuring product safety, quality, and compliance.
This training is tailored for professionals in the food and beverage industry, providing essential knowledge to ensure microbial safety and compliance with regulations.
CMETalk

This program highlights the advanced features of the Hycor NOVEOS Flex, addressing the limitations of current allergy testing technologies and offering innovative solutions for improved clinical outcomes.

Short for Continuing Medical Education, this program was designed by our technical team to equip with the mastery of cold chain management in healthcare.

Short for Continuing Medical Education, this is a program that was devised by our technical team with the aim to equip users with the skills and knowledge to effectively operate and maintain the TempGuard Monitoring System.
Real Feedback, Real Results
"I was able to identify how my cells from my project would act, the expectations, and the techniques for cell culture."
Taylor's University Lakeside Campus
Chow Suet May
“The insights gained on temperature monitoring for refrigerators have been extremely valuable."
Government Health Clinic
Nazirah Ilias
“The training was interactive and was handled well, the hands-on training made us understand the topics way better”
Manipal University
Arvind Nithyakumar
“We were able to identify and correct mistakes, leading to significantly better results."
Management & Science University (MSU)
Ropana A/P Buminazan
“Every topic is so helpful and easy to understand, very useful and relevant in lab work."
Universiti Sains Islam Malaysia (USIM)
Syarifah Khalilah Syed Yaziz
Discover our Full Education Offers
Access the complete FC-BIOS Education Kit - everything educational, all in one.
Our education series,
tailored-made for your lab needs.






In need of a customized session?
Contact us now to get your own personalized education slot!
